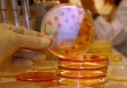

Les Nations Unies, Ban Ki-moon, a appelé la communauté internationale à prendre des mesures exceptionnelles face à l'épidémie d'Ebola qui a tué plus de 2.400 personnes en Afrique de l'Ouest.
«Ebola est une crise exponentielle qui exige une réponse mondiale exceptionnelle», a déclaré M. Ban lors d'une conférence de presse mardi au siège de l'ONU à New York.
Selon lui, les contributions annoncées jusque là restent insuffisantes eu égard de l'ampleur de la situation. « Nous avons beaucoup de choses à faire pour fournir les services sanitaires, la nourriture, l'eau, l'assainissement et les fournitures nécessaires», a-t-il souligné.
Le chef de l'ONU n'a pas manqué également de relever le problème des restrictions imposées au trafic aérien. «Nous ne pouvons pas laisser les interdictions concernant les voyages et les transports nous ralentir. Nous devons isoler les personnes touchées par Ebola, pas les pays qui se battent pour surmonter l'épidémie», a-t-il souligné.
«Il ne s'agit pas seulement d'une crise sanitaire. L'épidémie a des conséquences humanitaires, économiques et sociales graves qui pourraient se propager au-delà des pays touchés», a-t-il ajouté.
«Nous devons être aussi audacieux et courageux que ceux qui se battent sur la ligne de front de la maladie. C'est pourquoi, dit-il, l'Organisation des Nations Unies sera au centre de l'intervention pour lutter contre l'épidémie».
M. Ban Ki-moon a rappelé que le Conseil de sécurité tiendra une réunion d'urgence jeudi sur Ebola, au cours de laquelle la Directrice générale de l'Organisation mondiale de la santé (OMS), le Dr Margaret Chan, et lui-même présenteront le programme d'action internationale pour contenir cette menace.
C'est dans ce sens aussi que l'Assemblée générale des Nations Unies tiendra une réunion de haut niveau sur les besoins des populations et des pays touchés par Ebola.
L'épidémie d'Ebola continue de se propager en Afrique de l'Ouest avec près de 5.000 personnes infectées et plus de 2.400 morts en Guinée, au Libéria, au Nigeria, au Sénégal et en Sierra Leone, selon des chiffres de l'Organisation mondiale de la Santé (OMS).